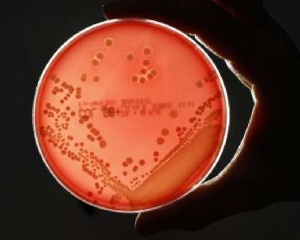

Новый контрастный агент, "подсвечивающий" микроорганизмы, находящиеся внутри человека, позволит врачам проводить более адекватное антибактериальное и оперативное лечение и сохранять большую часть конечности при ампутации.
Визуализация бактерий внутри организма позволит врачам быстро принимать решение по поводу назначения антибактериальных препаратов или проведения операции по удалению имплантата. После удаления имплантата визуализация поможет убедиться в полном уничтожении инфекции до внедрения нового протеза.
Основная проблема, связанная с разработкой подобных подходов, заключалась в том, что большинство связывающихся с бактериями молекул может накапливаться в тканях, воспаленных из-за присутствия инородного тела.
Разработанный специалистами Технологического института Джорджии агент лишен этого недостатка, он в больших количествах поглощается бактериальными клетками и не накапливается в окружающих тканях. Такая избирательность обусловлена наличием на поверхности бактериальных клеток белков, захватывающих углевод мальтогексаозу даже при условии, что к молекуле прикреплен визуализирующий агент. Клетки млекопитающих не имеют подобных белков и не способны поглощать модифицированный углевод.
Эксперименты на мышах продемонстрировали возможность использования комплекса мальтогексаозы с флуоресцентным белком для визуализации микроорганизмов в живом организме. Однако такой подход не позволяет выявлять инфекции глубоких тканей, так как испускаемый агентом свет поглощается тканями до выхода наружу.
Комментарии